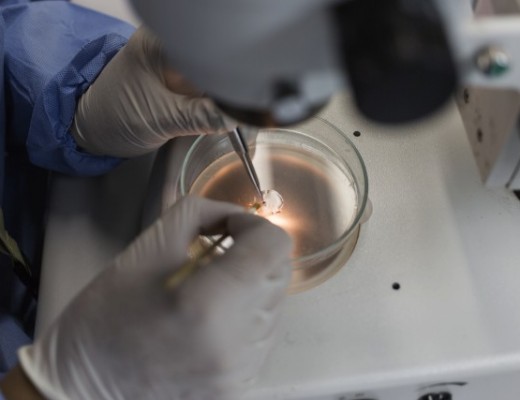
Image by © Flavio Forner/Xibe Images/Corbis

Did African travellers introduce the zika virus to Brazil? It’s highly unlikely
Africans are being blamed by doctors for bringing the mosquito-borne zika virus to South America, where an increase has been recorded in babies being born with an underdeveloped brain. Is that plausible? Sarah Wilde investigates.
In Brazil, 404 babies were born with microcephaly in 2015 – a disorder in which a foetus’s brain does not develop properly in the womb — with thousands more cases under investigation.

Of those, 17 babies were infected with the zika virus, a mosquito-borne disease, and 76 have died. Due to these developments, the World Health Organisation declared the zika outbreak a “public health emergency of international concern” earlier this month.
Health authorities are investigating whether zika, which was first discovered in Uganda, is behind the rise in microcephaly, and fingers have been pointed at African tourists for bringing the virus to Brazil. NPR reported earlier this month that “some doctors speculate it could have come with African visitors during the 2014 Football World Cup”.
Two doctors from the Saõ Paulo Institute for Tropical Medicine wrote that it was the “strongest hypothesis” for the outbreak of zika in Brazil.
Why were Africans under suspicion?
The Brazilian health authorities have not responded to numerous inquiries from Africa Check about whether they initially blamed African tourists for the zika outbreak, and whether they still do.
The closest that Africa Check could find was a statement by Brazilian president Dilma Rousseff: “The zika virus, transmitted by mosquito, has no nationality. It began in Africa, spread throughout Southeast Asia, the Oceania and is now in Latin America. And this was an exceptionally fast process, from last year.” (Note: This was translated using Google Translate, so excuse our Portuguese.)
How did the zika virus get to South America?
In a communique on the zika virus, the National Institute for Communicable Diseases says: “One could speculate that numerous introductions of either infected mosquitoes or infected travellers are necessary before a foreign arbovirus can become established in a new area, because the virus needs to be introduced into a capable vector population as well as host population.”
Asked how the virus could have arrived in Brazil, Failloux told Africa Check that it was more likely that it was brought by an infected traveller: “We cannot completely exclude an infected mosquito taking the plane [… but the] main and more realistic way to transfer the virus from one continent to another is through infected people.” The virus also causes no symptoms in 80% of cases, she said.
However, no countries from zika-virus-endemic Pacific countries competed in the 2014 Football World Cup, Didier Musso from the Institut Louis Malardé in Tahiti, French Polynesia, noted in a journal article.
Shortly thereafter though teams from the Pacific regions of French Polynesia, New Caledonia, Cook Islands and Easter Island – where the zika virus circulated in 2014 – competed in an international canoe sprint competition in Rio de Janeiro, Musso pointed out.
But even this is not a direct link to the current zika outbreak because it is possible that zika arrived in Brazil before that.
The first zika case in Brazil was confirmed with a laboratory test in May 2015, but “there were reports of ‘dengue-like syndrome’ occurring before this time,” the Centers for Disease Control and Prevention told Africa Check.
“It is more likely that the virus was already circulating and causing illness prior to May 2015, but had not been recognised as zika until later.”
Conclusion: Highly unlikely that an African traveller introduced zika to Brazil
Although the zika virus was first detected in Africa, three distinct strains of the virus now exist: the west and east African, and Asian. The Asian strain has been confirmed as the cause of Brazil’s zika cases.
It is possible that the virus was brought by an infected traveller – possibly from Oceania which had the first documented cases of zika outside of its endemic areas in Africa and Asia – during a sporting event, whether it was the 2014 Football World Cup or an international canoe sprint competition shortly thereafter.
It is, however, possible that the virus was present in Brazil before these events, and was misdiagnosed.
Credit: Africa Check, a non-partisan organisation which promotes accuracy in public debate and the media.
Follow them on Twitter @AfricaCheck or visit www.africacheck.org



